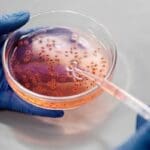
24 665ba92b2c360

நாட்டில் 24 லட்சம் குடும்பங்களுக்கு வழங்கப்படவுள்ள கொடுப்பனவு
இதுவரை அஸ்வெ சும நிவாரணம் கோரி விண்ணப்பிக்க முடியாதவர்களுக்கு இன்னும் வாய்ப்பு இருப்பதாக நிதி இராஜாங்க அமைச்சர் செஹான் சேமசிங்க (Shehan Semasinghe) தெரிவித்துள்ளார்.
எப்பாவளையில் அமைந்துள்ள லங்கா அரச பொஸ்பேட் நிறுவனத்தின் கண்காணிப்புச் சுற்றுப் பயணத்தில் கலந்துகொண்டு கருத்துத் தெரிவிக்கையிலேயே அமைச்சர் இதனைக் குறிப்பிட்டுள்ளார்.
அதன்படி, 2ம் கட்ட நிவாரணமாக ஜூலை முதல் 24 லட்சம் குடும்பங்களுக்கு இந்த கொடுப்பனவு வழங்க எதிர்பார்க்கப்படுவதாக அமைச்சர் குறிப்பிட்டுள்ளார்.
அத்துடன், இதுவரையில் அஸ்வெசும நிவராணப் பணத்திற்காக விண்ணப்பிக்காதவர்களுக்கு மேலதிக வாய்ப்பு வழங்கப்படும் என்றும் அவர் தெரிவித்துள்ளார்.
இதேவேளை, முதல் சுற்றில் 20 லட்சம் குடும்பங்களுக்கு நிவாரணம் வழங்க ஒப்புதல் அளிக்கப்பட்டுள்ளதாகவும் அமைச்சர் மேலும் கூறியுள்ளார்.